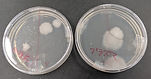
大気圧プラズマ 殺菌テスト

"初回 1週間無償レンタルサービス" 実施中
お客様のお手元で、お悩みの素材のテストが可能です
大気圧プラズマの効果をご確認ください
プラズマの力を、もっと身近に、もっと自由に。
大気圧プラズマは、熱にデリケートな素材や液体を含む素材さえも分子レベルで改質
あらゆる素材の眠っていた可能性を呼び覚まします
It's the light of my life
* プラズマジェットの写真は暗室にて高感度撮影を行っております。
(F1.8~F3.5 ISO1600~12800 1/2~1秒露光)
明るい室内では、写真のような鮮明なプラズマジェットの発光を目視するのは困難です。


プラズマは、固体・液体・気体に続く「物質の第4の状態」として知られ、
炎・オーロラ・雷・太陽といった自然現象にも存在するエネルギー形態です
株式会社アクアの大気圧プラズマ装置は、このプラズマを真空容器や特別な環境を必要とせず、通常の大気圧下で安定かつ安全に生成できる技術を用いて開発されています
真空設備が不要なため、装置構成を大幅に簡素化でき、省スペース化・低コスト化にも貢献します
当社が開発した低温大気圧プラズマは、素材への熱影響を最小限に抑え、
熱に弱い樹脂・フィルム・繊維・ゴムなどにも安心して使用できます。
また、従来の真空プラズマでは処理ができなかった減圧に適さない素材、水分や気体を含む素材・液体・ゲル状素材に対してもプラズマ処理が可能です
プラズマ中の活性種が材料表面の分子構造に直接働きかけ、「分子レベルでの表面改質」を実現することで、従来の処理では得られなかった性能や機能を引き出します
主な効果としては、
・親水性向上による濡れ性・液なじみの改善
・印刷・コーティング・特殊塗装・接着強度の向上
・洗浄では除去しきれない微細な有機汚れ・油膜の分解除去
・表面官能基の付加・化学反応の促進 など、
多岐にわたる用途で高い効果を発揮します。
また、当社装置は、手軽に使用できる卓上小型テスト機の他、装置サイズのカスタマイズ、工場規格に沿った安全対策など、お客様の用途に合わせた柔軟な設計が可能で、製造ラインへのインライン組込みにも対応しています。
株式会社アクアは、京都から高性能で扱いやすい大気圧プラズマ技術を提供し、表面処理・材料開発・製造プロセス革新に貢献してまいります
キャラクターデザイン、物語、写真、動画、音楽・・・全てAIで作成しています
最近、急速に発展している生成AIですが、SE経験のないプラズマ開発担当者が個人使用可能なレベルでどこまでできるのか・・・実験的なページです
日々アップデートされているGemini、Google AI Studio、ChatGPT、SUNOその他AIアプリ 最小限の課金でがんばります
生成AI活用ページ
イメージキャラクター誕生
New
プラズマとプラスチックのハイブリッド妖精
プラル
プラフィーナ
プラルとプラフィーナImage Music のページを新設しました。
ちょっと一息・・・ 妖精たちの世界をお楽しみください
New
歌詞はChatGPT、作曲はAI音楽生成アプリで作成しています
音楽用語も知らない素人の私でも本格的な曲が簡単にできてしまうので、音楽作成が趣味の同僚が隣で落ち込んでます・・・
画期的な技術革新に繋がる可能性を秘めた大気圧プラズマを少しでも世の中に広めたい!!
未来の発明家・研究者のみなさまへ
その研究、プラズマで加速させませんか?
【1週間 無料レンタルサービス】* 実施中!
-
まずは、気軽に試してみませんか?
【誰でもカンタン】
-
机に置けるコンパクトサイズで、操作は安全・シンプルです
-
コンセント(AC100V)と窒素ガスがあれば、すぐに使えます
【アイデアは無限大・画期的な発見に繋がる可能性】
-
真空(減圧)プラズマでは処理ができなかった水分や空気を含むもの、工夫次第で液体や粉、生物などにも照射できます
学生・研究者向けの特別プランもあります
-
詳しくは「メールでお問い合わせ」から、お気軽にご連絡ください。
*1週間を超えるレンタル、同一部所(学部)での2回目以降のレンタルは有償となります
装置返却時の送料はご負担お願い致しております
画期的な技術革新に繋がる可能性を秘めた大気圧プラズマを少しでも世の中に広めたい!!
大気圧プラズマガイドブック 第1版 全20ページ
熱い思いで作成しました
もう「大気圧プラズマは使えない」とは言わせない。 開発者が初めて明かす、”真実の効果”と”極秘ノウハウ”
数えきれないほどの試行錯誤と失敗を繰り返してきました。 その長年の大気圧プラズマ開発の歴史の中で掴んだ、これまで公開してこなかった”大気圧プラズマの真実”があります
大気圧プラズマって何? どのようなことができるの?
昔見たのはおもちゃのようなものだったけど、本当に使えるものなの?
親水化はしたけど、期待した効果は悪くなった?
以前借りてテストしたけど、効果がなかった ・・・これを読めば結果が変わるかもしれません
先端技術実現のきっかけとなる可能性も・・・技術大国日本の称号を再び!!
"メールでのお問い合わせは”からご請求ください (後日メールにて送付させて頂きます)
装置のご購入、初回1週間無償レンタル
サービスをご利用の際は、冊子を
同梱プレゼント致します
*申し訳ございませんが、同業者からのご請求はご遠慮させて頂く場合があります





メールでの
お問い合わせは
" 初回1週間無償レンタルサービス ”
「ウチの製品でも効くかな?」その疑問、直ちに解決します。まずはレンタルで効果を実感!
簡単操作で手軽に使える機種がそろっています。
レンタル
該当機種: HPJ-DESKTOP HPJ-02A SPJ-02HP/MIN HPJ-25SP DS-PJ1
クリックで詳細ページへ
その他の機種レンタルは要相談
お申込みの際は、右上の「メールでのお問合わせは」から、御一報頂けますと、申込書を返送させて頂きます。
お申込み多数の場合、数週間お待ち頂く場合がございます。お早めに御予約頂けますと幸いです。
1週間を超えてのお貸出、2回目以降のお貸し出しは有償となります
装置のご使用には、窒素ガスとAC100Vアース付き3Pコンセントが必要です(SPJ-02HP/MIN、HPJ-25SPは冷却用エアも必要です)
初回1週間無償レンタルサービスは装置返却時にテスト実施内容と結果、装置に対する評価とご要望などのアンケートに御協力をお願いしております
より良い装置開発、改良の参考にさせて頂きたいと考えております。機密事項に関わる内容は伏せて頂いて結構です。ご協力をお願いいたします
不可能を可能に、未来の技術を切り開く
大気圧プラズマ装置
簡単操作で本格的な大気圧プラズマ処理
詳しい情報は左の商品ラインナップをクリック
ちっちゃなダイレクトプラズマ
自動搬送卓上テスト機
小さくても、 実力は本物
自動搬送ユニットモデルチェンジ
FM-02A
デジタル流量計
プラズマ以外の用途でも使えます


汎用テスト機GPTMがモデルチェンジしました
試料台大型化、連続往復動作により、超長時間照射テストも可能です
高精細・フルカラー液晶パネルにより、様々な設定を行えます
照射幅108mmプラズマジェットJP-100C標準搭載
プラズマ電極部左右移動により200mm幅処理対応(*1)
<カスタマイズ例> 処理部安全カバー(ドアインターロック付き)
A4サイズワーク(210mm✕300mm)対応の大型タイプも製作可能です
詳細はお問い合わせください
プラズマジェット専用 GPTM2 標準機
GPTM2

カスタマイズ機 参考
A4サイズワーク対応、安全カバー付き、扉横開き
(*1) 電極左右自動移動は有料オプション
標準仕様は手動で左右移動可能
窒素ガス、冷却エア用 デジタル流量計ユニット
外付けデジタル流量計 FM-02A

手軽に流量調整・流量確認
ハンドバルブ、電源スイッチ付きになり、使いやすくなりました。
AC-DCアダプター付属 AC100Vコンセントのみでお使い頂けます
大気圧プラズマ用途以外の空気・窒素ガス流量調整にも使用できます
流量レンジに応じて3機種ご用意しました
展示会、イベント出展
2025年9月3(水)~5(金)に幕張メッセで開催の“JASIS 2025 最先端科学・分析システム& ソリューション展”の
“京都科学機器協会 ぶらり、京都”のブースに出展致しました
R.06 9月 4日(水)~ 6日(金) 幕張メッセで開催の “JASIS 2024最先端科学・分析システム&ソリューション展” に出展しました
R.06 2月15日(木)~16日(金) 京都パルスプラザ開催の京都ビジネス交流フェア2024に出展いたしました
R.05 9月 6日(水)~ 8日(金) 幕張メッセで開催の “JASIS 2023最先端科学・分析システム&ソリューション展” に出展いたしました
R.05 2月16日(木)~17日(金) 京都パルスプラザ開催の京都ビジネス交流フェア2023に出展いたしました
R.04 9月 7日(水)~ 9日(金) 幕張メッセで開催の “JASIS 2022最先端科学・分析システム&ソリューション展” に出展いたしました
R.03 11月 8日(月)~1 0日(水) 幕張メッセで開催の “JASIS 2021最先端科学・分析システム&ソリューション展” に出展いたしました
R.02 2月13日(木)~14日(金) 京都パルスプラザ開催の京都ビジネス交流フェア2020に出展いたしました
R.01 12月 4日(水)~ 6日(金) 幕張メッセ開催の “高機能フィルム展2019” に出展いたしました
H.31 2月14日(木)~15日(金) 京都パルスプラザで開催の “京都ビジネス交流フェア2019” に出展いたしました
H.30 12月 5日(水)~ 7日(金) 幕張メッセで開催の “高機能フィルム展” に出展いたしました
H.30 11月27日(火)~29日(木) インテックス大阪で開催の “中小企業 新ものづくり・新サービス展” に出展いたしました
H.30 2月15日(木)~16日(金) 京都パルスプラザで開催の “京都ビジネス交流フェア2018” に出展いたしました
H.29 12月 5日(火) マイドームおおさかで開催の”機能性コーティングフェア2017”に出展いたしました
H.29 11月27日(火)~30日(木) インテックス大阪で開催の “中小企業 新ものづくり・新サービス展” に出展いたしました
H.29 4月 5日(水)~ 7日(金) 東京ビックサイトで開催の “ 第8回 高機能フィルム展 ” に出展いたしました
H.29 3月 1日(水)~ 2日(木) 京都パルスプラザで開催の “京都ビジネス交流フェア2017” に出展いたしました
H.28 11月14日(月)~16日(水) インテックス大阪で開催の“ものづくり補助事業成果発表・ビジネスマッチング会「中小企業 新ものづくり・新サービス展」” に出展いたしました
国内外からの観光客で賑わう京都の夏の風物詩と言えば祇園祭
京都科学機器協会のテーマ " 祭り " に因んで、
新発売の小型大気圧プラズマテスト機DS-PJ1をベースにして
山鉾風の展示機を造ってみました
2025.9/3(水)~9/5(金)に、幕張メッセで開催された、
JASIS 2025 最先端科学・分析システム&ソリューション展の、
京都科学機器協会・ぶらり京都共同出展ブースに展示致しました
JASIS 2025では、新キャラクター プラルとプラフィーナを大量投入